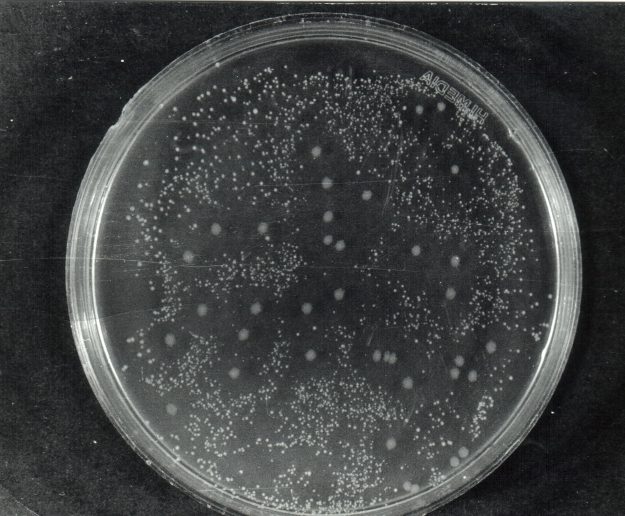
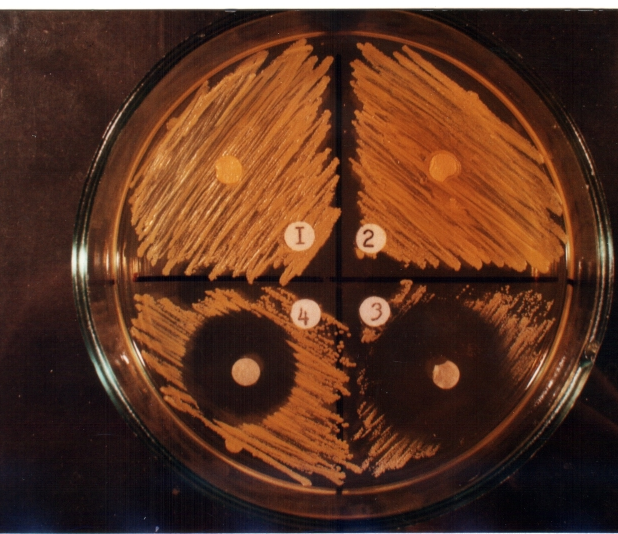
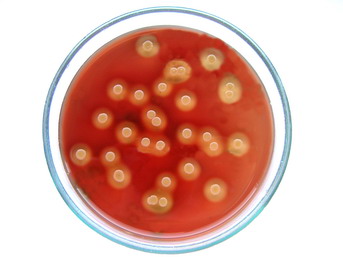
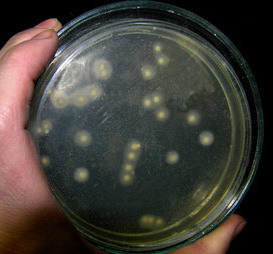
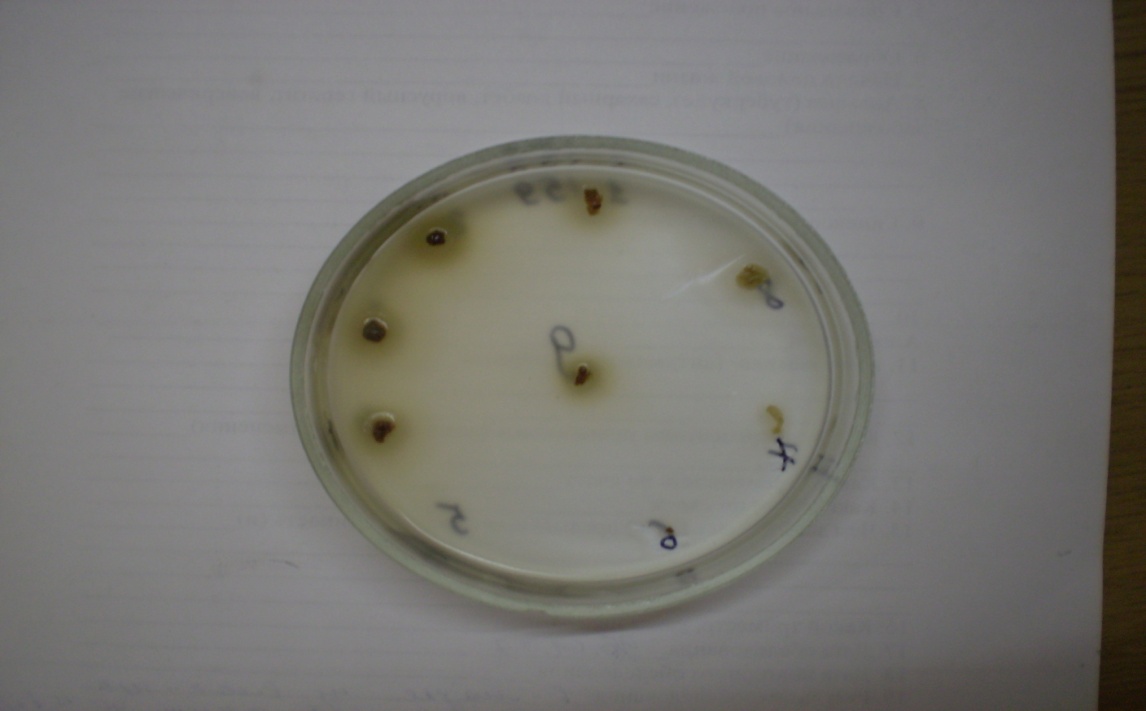
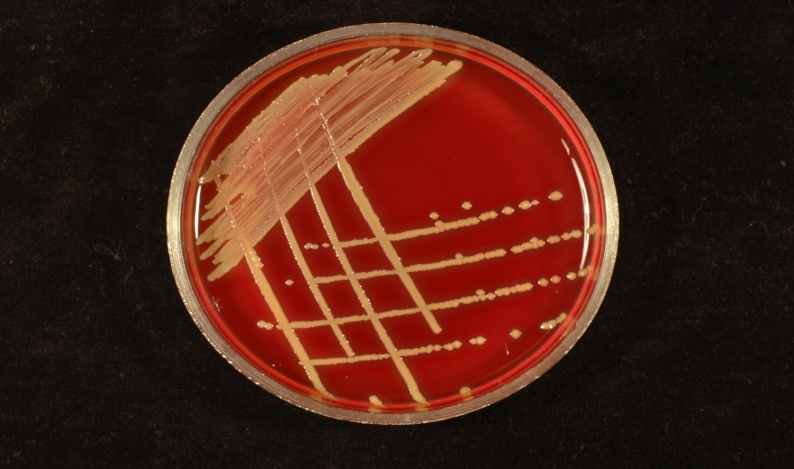
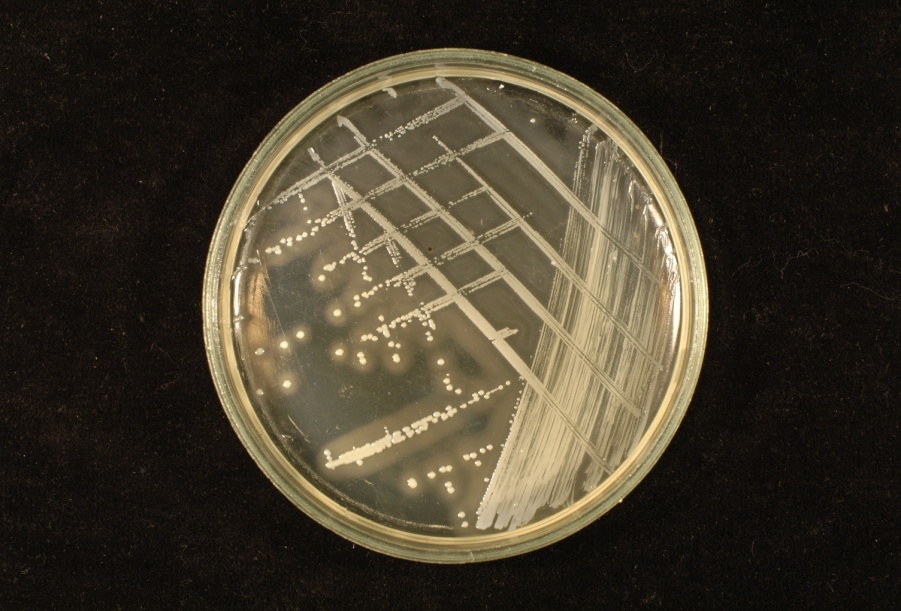
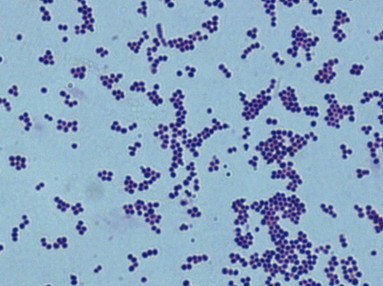
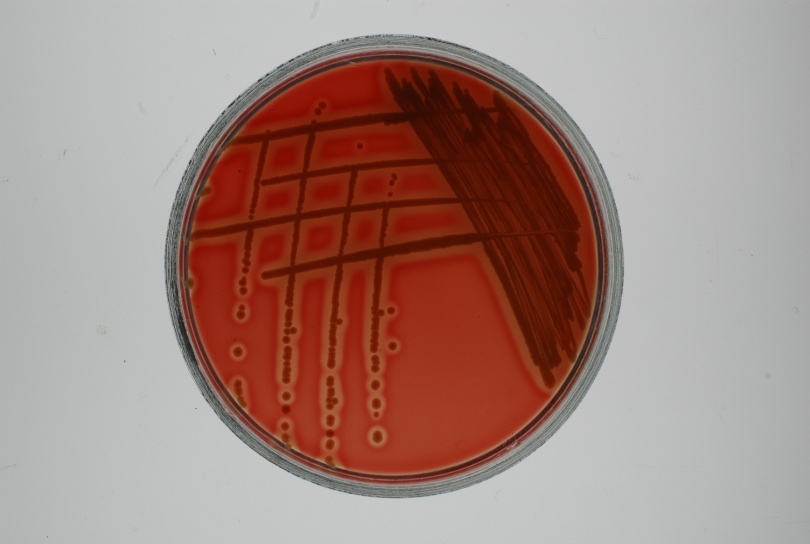
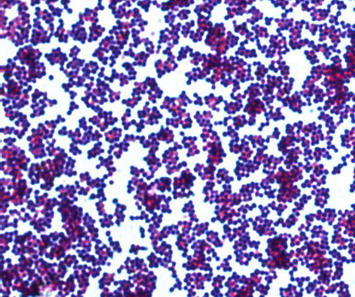
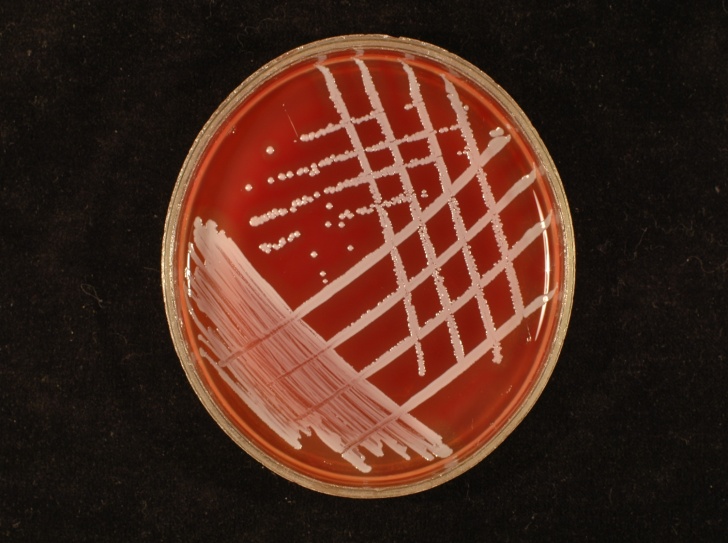
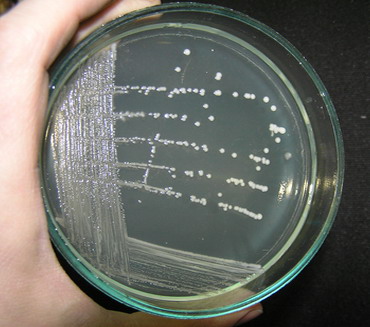
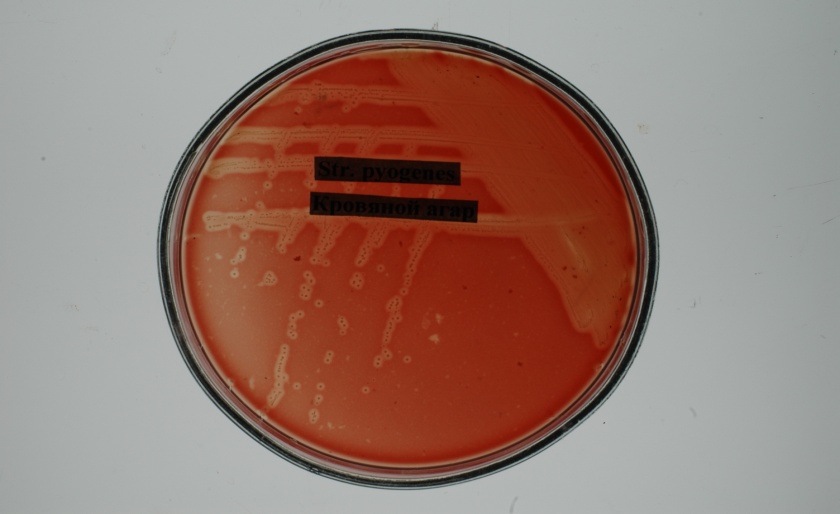
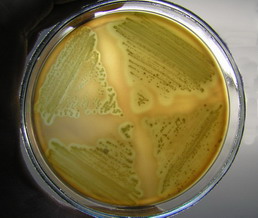
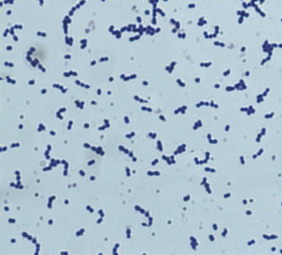
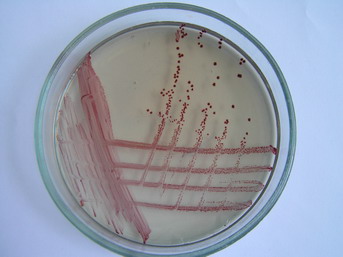
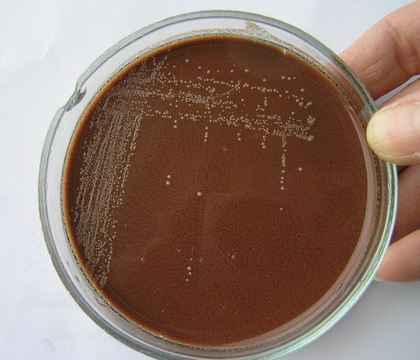
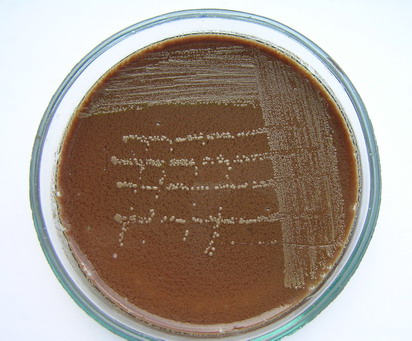
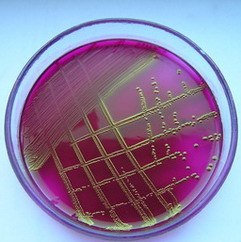
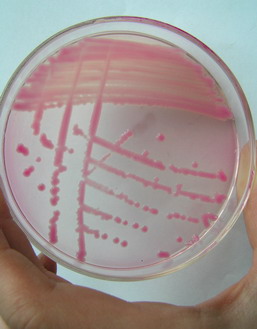
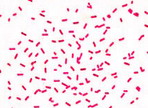
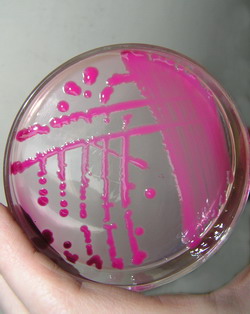
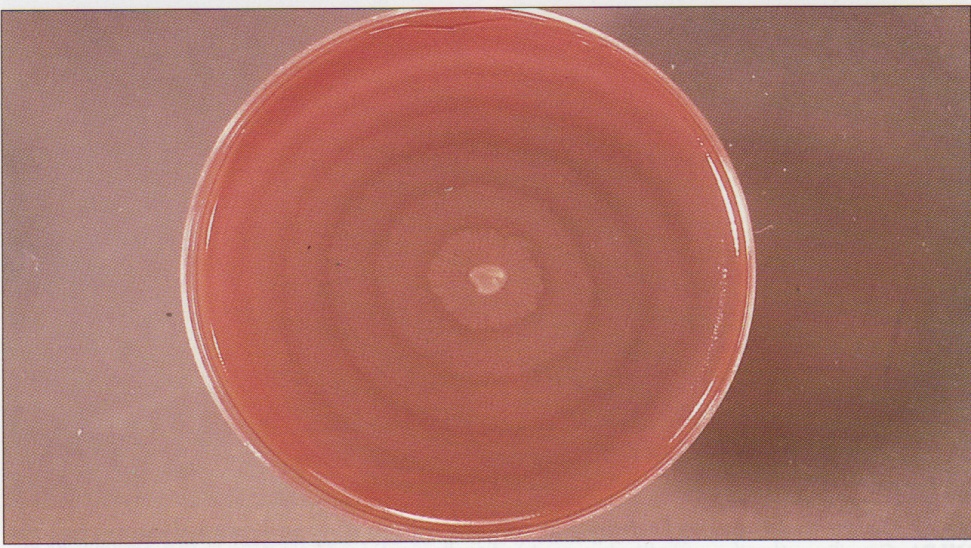
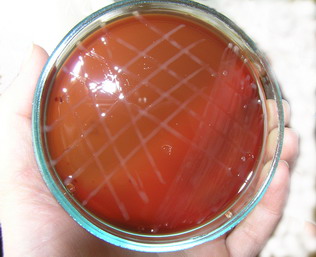
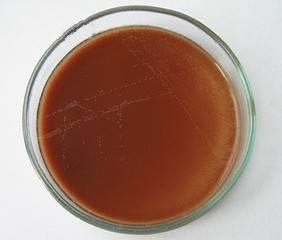
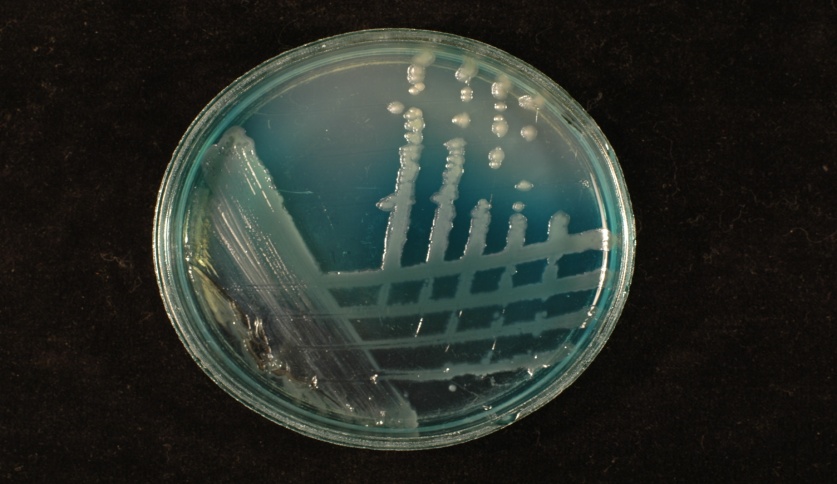
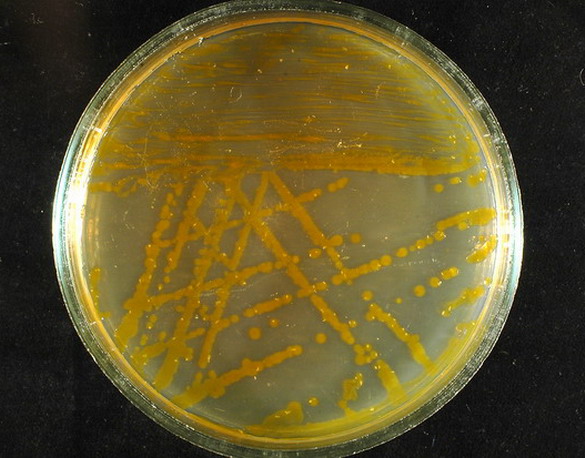
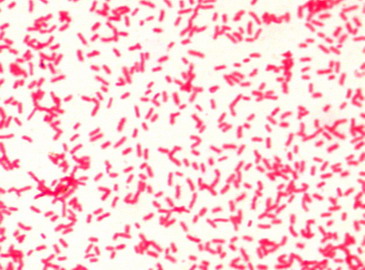
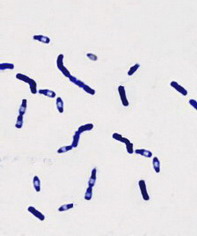
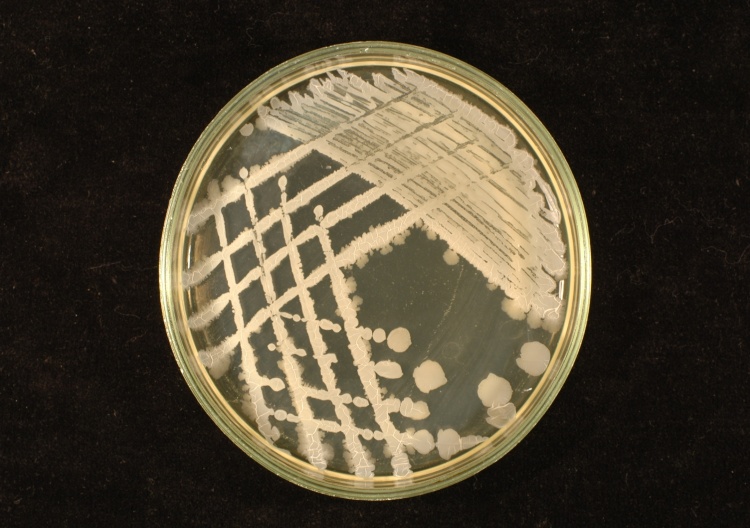
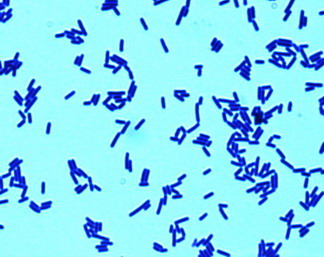
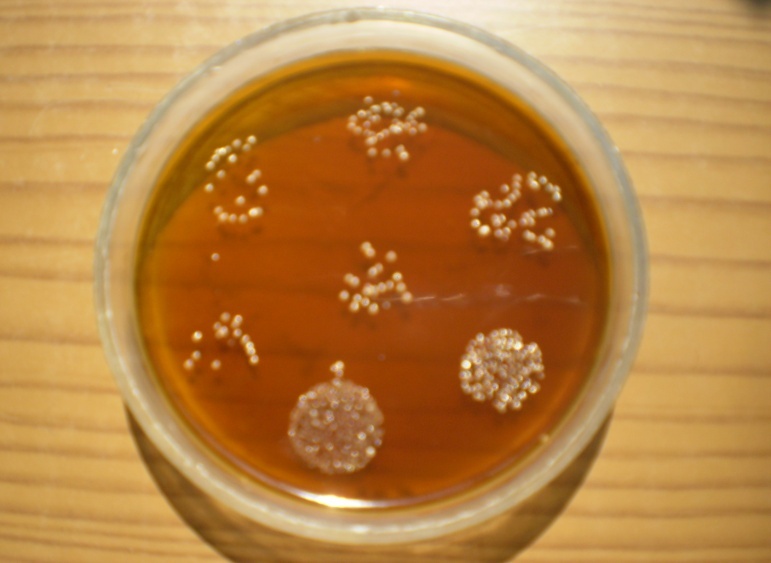
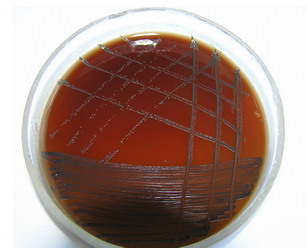
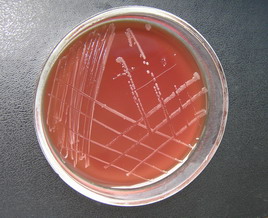
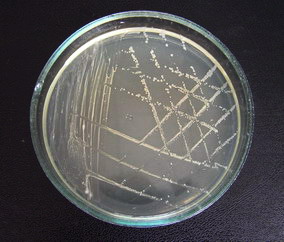
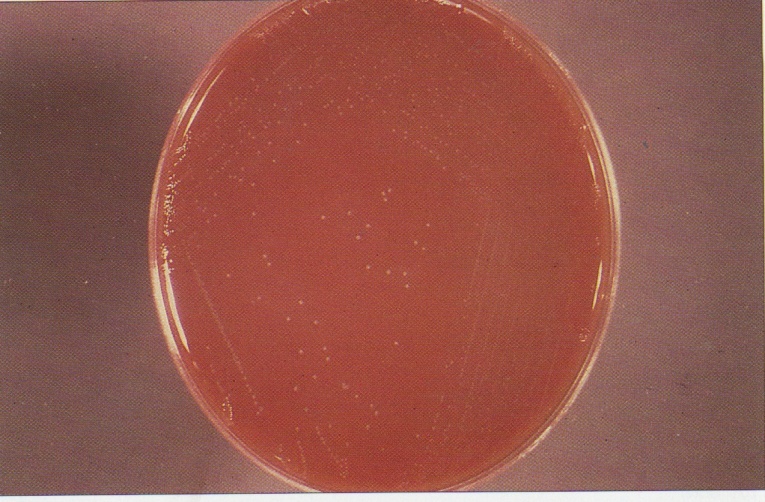
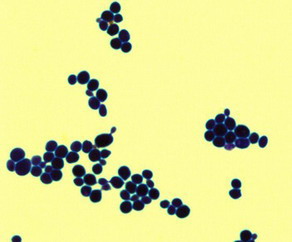
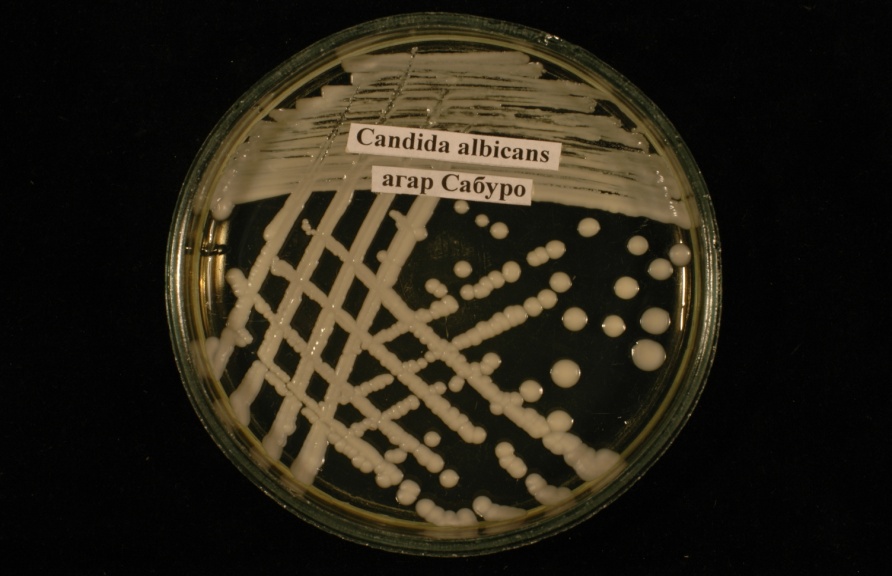
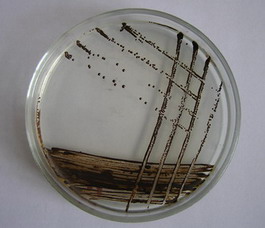

Штамм дегеніміз не?
A.Бір жасушадан алынған микроб дақылы
B.Жасанды қоректік ортада өсірілген микробтың бір түрінің популяциясы
C.Әртүрлі инфекция көзінен (аурулардан) немесе бір науқастан, бірақ әртүрлі уақытта бөлініп алынған микробтың бір түрінің дақылы.
D.Шығу тегі және генотипі ортақ, биологиялық қасиеттері бойынша
ұқсас, стандартты жағдайда ұқсас фенотиптік белгілерімен көрініс беретін
микроорганизмдер жиынтығы.
E. Бір жасушадан алынады
21.Бөлініп алынған микроб дақылын идентификациялау келесі қасиеттерін анықтаумен атқарылады:
A.Дақылдық
B.Биохимиялық
C.Тинкториалдық
D.Морфологиялық
E.Осы қасиеттерінің бәрін анықтаумен.
22.Сероварлар (анықтамасы, мысалы):
A.Антибиотиктерге төзімділігі бойынша айырмашалығы
бар микроорганизмнің бір түрі.
B.Антигендік қасиеті бойынша айырмашалығы бар бір түрге
жататын микроорганизмдер (Shigella flexneri,1,11 т.б.)
C.Әр жерден немесе сол жерден, бірақ әр түрлі уақытта бөлініп
алынған бір түрге жататын микроорганизм.
D.Биологиялық қасиеті бойынша айырмашалығы бар бір түрге
жататын микроорганизмдер (Vibrio choleraе, биоварлар «classic»,«eltor»).
E.Бактериофагтардың әртүрлі типтеріне сезімталдығы бойынша айырмашылығы
бар бір түрге жататын микроорганизмдер (Staphylococcus фаготип 1,2,15 т.б.)
23.Бактериологиялық зертханаларда анаэробтарды өсіру
үшін қолданылады:
A.Автоклав
B.Анаэростат
C.Пастер пеші
D.Дистиллятор
E.Кох аппараты
24.Вирустардың басқа микрооргнизмдерден ерекшелігтері:
A.ДНҚ мен РНҚ болады.
B.Меншікті энергетикалық жүйесі болады.
C.Ақуыз синтездеуші меншікті жүйесі болмайды.
D.Күрделі жасанды қоректік орталарда ғана өседі.
E.Шамалы мөлшерде меншікті рибосомалары бар.
25.Вирустардың репликациялану сатысына жататынды
көрсетіңіз:
A.Логарифмдік көбею
B.Жылдамдап қырылу
C.Көбеюдің керісінше тежелуі
D.Максимальды стационарлық фаза
E.Алғашқы және кешеуілді ақуыздар синтезделуі
26.Бактериофаг-ол:
A.Бактериялардың типтері.
B.Өсімдіктердің вирустары.
C.Бактериялардың вирустары.
D.Басқаларға антагонистік қасиеті бар бактериялар.
E.Бактерияларды қоршап алып жоятын макроорганизм жасушалары.
27.Вирустар репродукцияланады (көбейеді):
A.Бүршіктенумен
B.Екіге бөлінумен
C.Жыныстық жолмен
D.Дисъюнктивті тәсілмен
E.Сегменттерге бөлінумен
28. Вирулентті фагтың колониясы:
A.S –пішінді ақ түсті
B.Бұдырланған R-пішінді
C.Мөлдір таңдақтар сияқты
D.Томпақша, айналасы тегіс пигменттелген
E.Ортасы лайланған, айналасы мөлдір таңдақтар.
29. Вирустарды дақылдандырады:
A.Гисс ортасында
B.Эндо ортасында
C.Левин ортасында
D.Плоскирев ортасында
E.Тауық эмбрионында, жасуша дақылдарында.
30. Вирустың НҚ-ның рөлі:
A.Вирус геномын қорғайды.
B.Адгезиялық қызмет атқарады.
C.Тұқым қуалаушылық ақпарат тасымалдайды.
D.Жасушаға спецификалық жабысу рөлін атқарады
E.Микроорганизмнің қозғалғыштығын қамтамасыз етеді.
31.Микроорганизмдерде тұқым қуалаушылықтың материалдық
негізі болып табылады:
A.ДНҚ
B.Тимин
C.Рибоксин
D.Плазмокоагулаза
E.Мукополисахаридтер
32.Бактериялардың тұқым қуаламайтын - фенотиптік
өзгергіштігіне жатады:
A.Мутация.
B.Репликация.
C.Модификация.
D.Рекомбинация.
E.Трансформация.
33.Бактериялардың антибиотикке төзімділігіне жауапты
плазмидалар:
A.R–плазмидалар.
B.F–плазмидалар.
C.Ent–плазмидалар.
D.Col–плазмидалар.
E.Hly–плазмидалар.
34.Бактериостатикалық әсер ету –ол:
A.Вирустарды жою.
B.Спораларды жою.
C.Генетикалық рекомбинацияның бір түрі.
D.Вирустардың репродукциялануын тежеу.
E.Микроорганизмдердің өсіп-өніп көбеюін тоқтату
35.Стерилизация-ол:
A.Патогенді және ШПМ-ді жою.
B.Микроорганизмдердің өсіп-өнуін тоқтату.
C.Жұқпалы ауруларды тасымалдаушыларды (жәндіктерді)жою
D.Жасушалардың генетикалық аппаратына зақымдаушы әсер ету
E.Микроорганизмдердің кез келген түрін толық жою ( яғни кез келген
микробтан толық арылу)
36.Асептика –ол:
A. Емдеудің хирургиялық әдісі
B. Емдеу шараларының кешені
C Жарақаттағы микробтарды жою әдісі
D. Қалыпты микрофлораның құрамын реттеуге бағытталған
шаралар кешені
E. Жарақатқа (басқа да нысандарға) инфекция қоздырғышын түсірмеуге
бағытталған алдын-алу әдістері.
37.Зертханалық ыдыстар мен саймандардың бәрін стерильдеуге
мүмкіндік беретін әдіс:
A. Қайнату
B. Сүзгіден өткізу
C Пастеризациялау
D. Тиндализациялау
E. Автоклавта стерильдеу
38. Дезинфекциялаудың мақсаты:
A. Ауруханадағы объектілерді стерильдеу
B. Ұзаққа созылатын тұрақты иммунитет жасау
C. Бактериялардың генерациялық кезеңдерін қысқарту.
D. Ауру қоздырғыштарының таралып кетуіне жол бермеу
E. Бір микроорганизмнің көмегімен басқалардың тіршілігін тоқтату
39.Тиндализация- ол:
A. Спораларды жою
B. Ағымды бумен стерильдеу
C. Бөлшектеп стерильдеу әдісі
D. Иондаушы радияцияны қолдану
E. Бейспецификалық әсер ететін химиялық заттармен стерильдеу
40.Антибиотиктер өндіретіндер:
A. Вирустар
B. Вириоидтар
C. Бактериялар
D. Микоплазмалар
E. Қарапайымдылар
41.Антибиотиктер- ол:
A. Жарақаттағы микроорганизмдерді жою үшін қолданылатын химиялық немесе биологиялық заттектер.
B. Патогенді микроорганизмдерді жою мақсатында сыртқы орта объектілерін өңдеу үшін пайдаланылатын бейспецификалық әсер ететін химиялық заттектер
C. Спецификалық антимикробтық дәрмектер (бактериофагтар, иммундыглобулиндік препараттар).
D. Микроорганзмдердің өсіп-өнуін тоқтататын немесе оларды толық жоятын табиғи текті заттектер немесе олардың аналогтары.
E. Кейбір нысандарды микробтардан толық тазарту үшін қолданылатын химиялық агенттер.
42.Судың нәжістік ластануының көрсеткіші:
A. Протей
B. Стафилококк
C. Кейбір химиялық заттектер
D. Кандида саңырауқұлақтары
E. Ішек таяқшасы тобына жататын бактериялар
43.Емдеу-профилактикалық мекемелердегі ауаның санитариялық жағдайын анықтайды:
A. Улы заттар табумен
B. Сальмонеллалар болуымен
C. Термофильдік бактериялар саны бойынша
D. Ауаның A литріндегі ішек таяқшасының саны бойынша
E. Ауаның 1м3 көлеміндегі жалпы микробтар саны бойынша
44.Санитарлық-көрсеткіш микроорганизмдерге жатады:
A. Актиномицеттер
B. Қарапайымдылар
C. Тырысқақ вибрионы
D. Споратүзуші бациллалар
E. Ішек таяқшасы, стафилококтар
45.Егер ағзаның өзі иммунитет түзуге қатынасса, онда ол:
A. Белсенді
B. Енжарлы
C.Антимикробтық
D.Антитоксикалық
E. Табиғи енжарлы
46.Егер иммунитет дайын антиденелерден кейін қалыптасса, онда ол:
A.Енжарлы
B. Белсенді
C. Антимикробтық
D. Антитоксикалық
E. Табиғи енжарлы
47.Анасынан тараған иммунитет:
A.Енжарлы
B.Белсенді
C.Антимикробтық
D.Антитоксикалық
E.Табиғи енжарлы
48.Микробтарға қарсы иммунитет:
A.Табиғи
B. Енжарлы
C. Белсенді
D. Антимикробтық
E. Антитоксикалық
49.Лизоцизм:
A.Тері құрамындағы ақуыз
B.Сілекей құрамындағы ақуыз
C.Лимфоциттер синтездейтін өнім
D.Иммунды реакциялардың медиаторы
E.Серологиялық реакцияларда қолданылатын зат
50.Біріншілік иммунды тапшылық
A.Туа біткен
B. Дәрінің әсерінен
C. Өмірде кездеспейді
D. Макрофаг қолдауымен
E. Жұқпалы аурудан кейін
51.Антиген :
A.Микробтарда болмайды
B.Тек қана вирустарда болады
C.Тек қана хламидияларда болады
D.Тек қана қарапайымддыларда болады
E. Генетикалық бөгде информацияны тасымалдайтын заттар
52.Антиденелер :
A. Альбуминдер
B. Иммундыглобулиндер
C. Комплемент фрагменті
D. Қан сарсуының қалыпты глобулиндері
E. Ақуызбен көмірсутегінің байланысы
53.Екіншілік иммунды жауап мынаған байланысты
A. Агаммаглобулинемияға
B. Иммунды сарсуды енгізуіліне
C. Иммунологиялық есте сақтауға
D. Иммунологиялық толеранттыққа
E. Комплемент жүйесінің белсендірілуіне
54.Антидененің табиғаты
A. Протеиндер (акуыздар)
B. Көмірсутегі
C. Липопротеид
D. Гликопротеид
E. Нуклеопротеидтер
55.Серологиялық реакциялар деп атайды:
A. Химиялық реакцияларды
B. Сарсу қолданылатын реакцияны
C. Антигенді анықтайтын реакцияны
D. Ферменттерді анықтау үшін қолданылатын реакцияны
E. Т және В-лимфоциттерді анықтау үшін қолданылатын реакцияларды
56.Иммунитеттің бейспецификалық гуморальді факторына жатады:
A. Агглютининдер
B. Гемагглютинин
C. Бактериофагтар
D. Комплемент және пропердин жүйесі
E. Жасушалық иммунитеттің медиаторлары
57.Вакцина мынаны құру үшін қолданылады:
A. Тумыстан болған иммунитетті
B. Енжарлы спецификалық иммунитетті
C.Белсенді спецификалық иммунитетті
D. Енжарлы спецификалық емес иммунитетті
E. Белсенді спецификалық емес иммунитетті
58.V1-антиген:
A.Қыздырғанда бұзылады
B. Барлық микробтарда болады
C. Вирустың антигеніне жатады
D. Вирулентті штаммдарда болады
E. Антидененің түзілуін тудырмайды
59.Фагоцитоз – ол:
A. Фогоциттердің қалыптасу процесі
B. Фагоцитарлы медиаторлар синтезі
C. Микробтардың желімделу реакциясы
D. Микробтарды жұту және қорыту процесі
E. Иммунды жасушаның антигенге қарай қозғалуы
60.Іш сүзегі ауруының І-аптасында бактериологиялық диагноз қою үшін қолданылады:
A. Видаль реакциясын қою
B. Өтінен себінді жасау (билидақыл)
C. Нәжісінен себінді жасау (копродақыл)
D. Несебінен себінді жасау (уринодақыл)
E. Қанынан қоздырғышын табу (гемодақыл)
61.Көрсетілген энтеробактериялардың қайсысының екі фазалық Н-антигені бар:
A. Шигеллалардың
B. Иерсиниялардың
C. Эшерихиялардың
D. Клебсиеллалардың
E. Салмонеллалардың
62.Іш сүзектік бактериялар тасмалдаушылықты анықтау үшін қолданылады:
A. Гемодақыл бөліп алу
B. Нәжісінен себінді жасау
C. Vi-гемагглютинациялық реакция қою
D. О-диагностикуммен Видаль реакциясын қою
E. Поливалентті сарысулармен агглютинациялық реакция қою
63.Тырысқақ вибрионының тинкториалдық және морфологиялық қасиеті:
A. Грам (-), перитрихтар
B. Грам (-), коккобактериялар
C. Грам (+), споратүзуші таяқшалар
D. Грам (+), спираль пішінді бактериялар
E. Грам (-), монотрихты қозғалғыш үтір тәріздес
64.Тырысқақ қоздырғыштарына тән ортақ антиген:
A.К-Аг
B.Н-Аг
C.Vi-Аг.
D.О1-Аг
E.Протективті Аг
65.Тырысқақ диагнозын қоюдың экспресс-әдісін көрсетіңіз:
A.Аллергиялық
B.Биологиялық
C.Серологиялық
D.Бактериологиялық
E.Тырысқақтық сарысумен вибриондарды иммобилизациялау (қозғалысын тоқтату)
66.Тырысқақ вибрионына қажетті элективті қоректік ортаны көрсетіңіз:
A. Сілтілі агар
B. Эндо ортасы
C. Плоскирев ортасы
D. Сарысулы-тұзды агар
E. Висмут-сульфитті агар
67.Тырысқақ диагнозын қоюдың ретроспективті әдісін таңдаңыз:
A. КБР
B. Копродақыл бөліп алу
C. Қоздырғыштың токсигенділігін анықтау
D. Вибрионоцидті антиденелерді анықтау
E. Асколи бойынша преципитациялық реакция қою
68.Психрофилды бактерияларға жатады:
A. Шигеллалар
B. Иерсиниялар
C. Эшерихиялар
D. Клебсиеллалар
E. Салмонеллалар
69.Ішек иерсиниозының қоздырғышы:
A. I. pestis
B. I. intermedia
C. I. kristensenii
D. I. enterocolitica
E. I. pseudotuberculosis
70.Науқастың нәжісінен Эндо ортасында грам (-), биполярлы боялған, спора және капсула түзбейтін, қозғалғыш таяқшалар бөлініп алынды. Бұл дақыл энтеробактериялардың қандай туыстастығына (род) жатады?
A. Proteus
B.Iersinia
C. Shigella
D. Klebsiella
E. Escherichia
71.Кампилобактериоз қоздырғышы жататын тұқымдастық:
A. Bacillaceae
B. Spirillaceae
C. Brucellaceae
D. Micrococcaceae
E. Enteriobacteriaceae
72.Іші өтіп ауырған науқастың нәжісінен дайындалған жағындыда грам (-), жіңішке спираль пішінді, кейбіреулері «шағала қанаты» тәріздес бактериялар табылды. Қандай микроб туралы ойлайсыз?
A. Протей
B. Иерсиниялар
C. Ешерихиялар
D. Тырысқақ вибрионы
E. Кампилобактериялар
73.Кампилобактериоз диагнозын қоюдың негізгі әдісі:
A. Генетикалық
B. Биологиялық
C. Аллергиялық
D. Серологиялық
E. Бактериологиялық
74.Асқазан және онекі елі ішекте ойық жара қоздыруға себепкер болатын микроб:
A. Helicobacter pylori
B. Campylobacter coli
C. Campylobacter fetus
D. Campylobacter jejuni
E. Campylobacter sputorum
75.Бруцеллез кезінде қойылатын аллергиялық сынама:
A. Дик сынама
B. Шик сынама
C. Манту сынама
D. Бюрне сынама
E. Мицуда сынамасы
76.Оба ауруының алдын алу үшін қолданылатын препарат:
A. СТИ
B. БЦЖ
C. ТАВte
D. Анатоксин
E. EV штамынан дайындалған тірі вакцина
77.Туляремия кезінде экспресс-диагноз қою үшін қолданылады:
A. ПГАР
B. «Ілінген тамшы» әдісі
C. Қанды-тамшылы реакция
D. Анотоксинмен сынама қою
E. Түнек айдынды микроскопта қарау
78.Күл (дифтерия) таяқшасын бөліп алу үшін пайдаланылатын қоректік орта:
A. ЕПА
B. Сілтілі агар
C. Вильсон-Блер ортасы
D. Висмут-сульфитті агар
E. Қанды-теллуритті орта
79.Бабеш-Эрнст (волютин) дәндерін анықтау үшін қолданылатын бояу әдісі:
A. Гисс
B. Нейссер
C. Ожешко
D. Гинс-Бурри
E. Циль-Нильсен
80.Коринебактериялардың (күл таяқшасының) токсигенділігін анықтау үшін қолданылады:
A. КБР
B. ПТР
C. ИФР
D. Раит реакциясы
E.Оухтерлони әдісі
81.Клауберг ортасындағы дифтерия таяқшасының gravis биовариантының өсіндісінің сипаты:
A. Сынап тамшысы тәріздес
B. Қою-қызыл түсті колониялар
C. Ашық-сары түсті колониялар
D. Томпақ бетті дөңгелек тәріздес колониялар
E. Дәстүргүл (маргаритка) тәріздес колониялар
82.Коринебактериялардың цистиназа ферментін анықтау үшін қолданылатын әдіс:
A. ПТР
B. ПГАР
C. Пизу сынамасы
D. Заксе сынамасы
E. Пирке сынамасы
83.Анэробты газды инфекция қоздырғышын дақылдандыру үшін пайдаланылады:
A. Уленгут ортасы
B. Леффлер ортасы
C. Никкерсон ортасы
D. Вильсон-Блер ортасы
E. Левенштейн-Иенсен ортасы
84.Ботулизм кезінде микробиологиялық диагноз қою үшін қолданылады:
A. ПГАР
B. Дик сынамасы
C. Асколи реакциясы
D. Агглютинациялық реакция
E. Ақ тышқандарға бейтараптау реакциясын қою
85.Сіреспе қоздырғышының патогенділігі төмендегілердің қайсысымен байланысты:
A. Эндотоксинмен
B. Фибринолизинмен
C. Экзотоксиндермен
D. Нейраминидазамен
E. Плазмокоагулазамен
86.Ботулизм ауруын емдеу үшін пайдаланады:
A. Бактериофагты
B. Аутовакцинаны
C. Антибиотиктерді
D. Антимикробтық сарысуды
E. Антитоксиндік поливалентті сарысуды
87.Спора түзетін, грам (+), анаэробты таяқшалварға жатады:
A.Clostridium
B. Leptotrichia
C. Baocteroides
D. Fusobacterium
E. Campylobacter
88.Ауруханаға ер кісі және әйел жеткізілді. Басының қатты ауыратынына, ішінің желдеуіне, лоқсу, құсу, көзіне екеу болып көрінетініне, жұтынуының қиындығына шағым айтады. Кешкісін екеуі де үй жағдайында дайындалған консервіленген баклажан жеген. Осындай ауруды қандай микроб тудыруға себепкер болды?
A. E. coli
B. C. tetani
C. B. anthracis
D. C. botulinum
E. C. perfringens
89.Бала бақшада балалар арасында қызылшамен ауырған бірнеше оқиға болды. Басқа балаларды ауруға шалдықтырмау үшін балалардың бәріне енгізеді:
A. Анатоксин
B. Өлі вакцина
C. Бактериофаг
D. Тірі вакцина
E. Арнайы иммундыглобулин
90.Қызамық вирусы жататын туыстастық:
A. Poxvirus
B. Rubivirus
C. Togavirus
D. Adenovirus
E. Enterovirus
91.Паротиттің спецификалық профилактикасы үшін қолданылады:
A. Анатоксин
B. Бактериофаг
C. Тірі вакцина
D. Антибиотиктер
E. Химиялық вакцина
92.Ұшық вирусы қоздыратын инфекциялардың спецификалық профилактикасы үшін пайдаланылады:
A. Анатоксин
B. Тірі вакцина
C. Аутовакцина
D. Гаммаглобулин
E. Инактивацияланған вакцина
93.ВГВ арнайы профилактикасы үшін қолданылады:
A. Тірі вакцина
B. Альфа-интерферон
C. Иммундыглобулин
D. Гендік-инженерлік вакцина
E. Инактивацияланған вакцина
94.ВГВ-на тән антигенді көрсет:
A. Нbs- антиген
B. O-H- антиген
C. Гемагглютинин
D. Капсулалық антиген
E. Протективті антиген
95.АИВ (ВИЧ) зақымдайды:
A. Бұлшықеттерді
B. Сілекей бездерін
C. Адамның иммундық жүйесін
D. Шеткейлік нерв жасушаларын
E. Жұлынның алдыңғы мүйізінің жасушаларын
96.АИВ-ның геномының құрылымдарына кіреді:
A. Сызықшалы ДНҚ
B. Екі жіпшелі (-) РНҚ
C. Сегменттелген РНҚ
D. Спиральданған ДНҚ
E. (+) РНҚ-ның екі жіпшесі
97. ЖИТС (СПИД) вирусы жататын тұқымдастық:
A Adenoviridae
B Reoviridae
C Poxviridae
D Retroviridae
E Hepadnoviridae
98.Жасуша дақылы өсірілген пробирканы микроскопта қарағанда пішіні өзгерген жасушалар көрінеді, кейбіреулері пробирка қабырғасынан ажырап кеткен, қоректік ортаның түсі – қызыл. Мұндай өзгерістер нені дәлелдейді?
A. ЦПӘ (ЦПД) болғанын
B. Жасушаның өсіп-өнгенін
C. Интерферон бар екендігі
D . Қоректік ортада лизоцим бар екендігін
E. Протеолиттік ферменттердің әсер еткенін
99.Вирусологиялық зертханаға энтеровирустық инфекцияға күмәнді баланың нәжісі әкелінді. Зерттеу заты жаңа туылған ақ тышқандарға және жасуша дақылына жұқтырылды. Бөліп алынған вирус жаңа туылған ақ тышқандарға патогенді және жасуша дақылдарында ЦПІӘ тудырады. Қандай вирус туралы ойлайсыз?
A. ЕСНО
B. Коксаки
C. Поливирус
D. Ұшық вирусы
E. А гепатит вирусы
100.Грипп вирусының беткейлік антигені:
A. GP-41
B. GP-120
C. Нbs- антиген
D. Нейраминидаза (N)
E. Нуклеопротеинді антиген (NP)
Тест сұрақтарына жауаптар
| Сұрақ № | Жауабы | Сұрақ № | Жауабы | Сұрақ № | Жауабы | Сұрақ № | Жауабы |
| A | C | E | E | ||||
| C | D | B | C | ||||
| C | C | C | E | ||||
| E | E | A | B | ||||
| E | C | B | E | ||||
| E | A | D | E | ||||
| E | C | C | C | ||||
| D | A | D | D | ||||
| D | E | D | E | ||||
| C | E | E | C | ||||
| D | E | E | E | ||||
| A | E | C | A | ||||
| B | D | E | D | ||||
| E | C | D | E | ||||
| D | C | E | B | ||||
| A | D | A | C | ||||
| A | E | D | E | ||||
| D | E | B | D | ||||
| D | E | D | A | ||||
| C | A | B | C | ||||
| E | A | B | E | ||||
| B | E | E | D | ||||
| B | D | E | A | ||||
| C | B | A | B | ||||
| E | A | D | D |
Қосымшалар
| |
| |
| |
| |
| |
| |
| |
| |
| |
| |
| |
| |
| |
| |
| |
| |
| |
| |
| |
| |
| |
| |
| |
| |
| |

| 

| ||||||||||||
| Түнек айдынды стереомикроскоп (а)филярия, (б)стронгилоидтар | |||||||||||||
| 1-сурет | |||||||||||||

| |||||||||||||
| 2-сурет | |||||||||||||

| 
| ||||||||||||
| Электрондық микроскоппен қараған кездегі сальмонеллалар жасушасының құрылымы. | |||||||||||||
| 3-сурет. | |||||||||||||

| 
| ||||||||||||
| 4(а) сурет. Монодақылдағы Staph. aureus (электронограмма). ВКС – жасуша қабырғасының ішкі қабаты, СКС – жасуша қабырғасының ортаңғы қабаты, НКС – жасуша қабырғасының сыртқы қабаты, ЦМ – цитоплазмалық мембрана, Я – ядролық субстанция; 4(б) - сурет. Жоғарыдағы штамм бөліну барысында. ПП- көлденең перде, КС – жасуша қабырғасы. | |||||||||||||

| 
| ||||||||||||
| 5(а) сурет. S. pneumoniae үш жасушаға бөлінген (элетронограмма) М- медосома, ПП- көлденең перде, П – көлденең перденің басталуы; | 6(б) - сурет. S. Pneumoniae бірнеше жасушаға бөлінуі (электронограмма) ; Д- бөлу перделері. | ||||||||||||

| |||||||||||||
| «Медициналық микробиология жэне иммунология бойынша атластан» алынды. Редакторлары А.А Воробьев, А.С.Бойков,М.2003,МИА.100 бет | |||||||||||||
| 6-сурет | |||||||||||||

| 
| ||||||||||||
| 7-сурет | 8-сурет | ||||||||||||

| 
| ||||||||||||
| 9-сурет | 10-сурет | ||||||||||||

| 
| ||||||||||||
| 11-сурет | 12-сурет | ||||||||||||
| «Медициналық микробиология жэне иммунология бойынша атластан» алынды. Редакторлары А.А Воробьев, А.С.Бойков,М.2003,МИА.100 бет | |||||||||||||
        13-сурет. Ретровирустардың репродукциялану кезеңдері
13-сурет. Ретровирустардың репродукциялану кезеңдері
| |||||||||||||

| 
| ||||||||||||
| «Медициналық микробиология жэне иммунология бойынша атластан» алынды. Редакторлары А.А Воробьев, А.С.Бойков,М.2003,МИА.100 бет | |||||||||||||
| 14-сурет | |||||||||||||
| Микробаралық өзара қатынастар | |||||||||||||
|
| ||||||||||||
| Лактобактериялардың екі түрінің арасындағы табиғи интерференциялық құбылыс (антогонизмі) 1 - L.salivarius , 2 - L.fermentum | 1,2- S.epidermidis және S.saprophyticus штамдарының арасындғы комменсализм 3. S.aureus штамының S.epidermidis өсуін басып тастауы. 4. S.epidermidis өсуін S.epidermidis- тің басқа штамының басып тастауы | ||||||||||||
| 15- сурет | |||||||||||||
| S.aureus патогенділік факторы | |||||||||||||
|
| ||||||||||||
| Гемолизин | Лецитиназа | ||||||||||||

|
| ||||||||||||
| ДНК - аза | Оң нәтижелі хемотаксис | ||||||||||||
| 16- сурет | |||||||||||||
| Micrococcus luteus | |||||||||||||

|
| ||||||||||||
| Грам әдісімен боялған | Қанды агардағы өсіндісі | ||||||||||||
| 17-сурет | |||||||||||||
| Staphylococcus aureus | |||||||||||||
| |||||||||||||
| Грам әдісімен боялған | СТА-дағы өсіндісі | ||||||||||||

|
| ||||||||||||
| Грам әдісімен боялған | Қанды агардағы өсіндісі | ||||||||||||
| 18-сурет | |||||||||||||
| Staphylococcus epidermidis | |||||||||||||
|
| ||||||||||||
| Грам әдісімен боялған | Қанды агардағы өсіндісі | ||||||||||||
| 19-сурет | |||||||||||||
| Staphylococcus saprophyticus | |||||||||||||

|
| ||||||||||||
| Грам әдісімен боялған | ЕПА-дағы өсіндісі | ||||||||||||
| 20-сурет | |||||||||||||
| Streptococcus pyogenes | |||||||||||||

|
| ||||||||||||
| Грам әдісімен боялған | Қанды агардағы өсіндісі | ||||||||||||
| 21-сурет | |||||||||||||
| Streptococcus mitis | |||||||||||||

|
| ||||||||||||
| Грам әдісімен боялған | Қанды агардағы өсіндісі | ||||||||||||
| 22-сурет | |||||||||||||
| Streptococcus pneumoniae | |||||||||||||

| 
| ||||||||||||
| Нативті жағынды, метиленді көкпен боялған | Қанды агардағы α- гемолиз | ||||||||||||
| 23-сурет | |||||||||||||
| Enterococcus faecalis | |||||||||||||
|
| ||||||||||||
| Грам әдісімен боялған | Энтерококтық агардағы өсіндісі | ||||||||||||
| 24- сурет | |||||||||||||
| Neisseria | |||||||||||||

|
| ||||||||||||
| Neisseria sicca. Грам әдісімен боялған | Шоколадты агардағы өсіндісі | ||||||||||||

|
| ||||||||||||
| Neisseria elongata. Грам әдісімен боялған | Шоколадты агардағы өсіндісі | ||||||||||||
| 25-сурет | |||||||||||||
| Escherichia coli | |||||||||||||

|
|
| |||||||||||
| |||||||||||||
| Грам әдісімен боялған | Эндо ортасындағы лактозаыдыратушы колониялар | Эндо ортасындағы лактозаыдыратпаушы колониялар | |||||||||||
| 26-сурет | |||||||||||||
| Klebsiella pneumoniaе | |||||||||||||

| 
|
| |||||||||||
| Бурри-Гинс бойынша капсуласын бояу | Грам әдісімен боялған | Эндо ортасындағы өсіндісі | |||||||||||
| 27-сурет | |||||||||||||
| Proteus mirabilis | |||||||||||||

|
| ||||||||||||
| 28- сурет | |||||||||||||
| Campylobacter jejuni | |||||||||||||

|
| ||||||||||||
| Грам әдісімен боялған | Қанды агардағы өсіндісі | ||||||||||||
| 29-сурет | |||||||||||||
| Haemophilus influenzae | |||||||||||||

|
| ||||||||||||
| Грам әдісімен боялған | Шоколадты агардағы өсіндісі | ||||||||||||
| 30-сурет | |||||||||||||
| Pseudomonas aeruginosa | |||||||||||||
|
| ||||||||||||
| Көк-жасыл пигмент | Сары пигмент | ||||||||||||
| 
| 
| |||||||||||
| Грам әдісімен боялған | Жасыл пигмент | Қоңыр пигмент | |||||||||||
| 31-сурет | |||||||||||||
| Bacillus | |||||||||||||
| 
|
| |||||||||||
| Грам әдісімен боялған | Ожешко әдісімен бояу | ЕПА-дағы өсіндісі | |||||||||||
| 32-сурет | |||||||||||||
| Clostridium | |||||||||||||

| 
| ||||||||||||
| Грам әдісімен боялған | Сидоренко әдісімен бояу | ||||||||||||
| 33-сурет | |||||||||||||
| Lactobacillus | |||||||||||||
|
| ||||||||||||
| Грам әдісімен боялған | Рогозы aгарындағы өсіндісі | ||||||||||||
| 34-сурет | |||||||||||||
| Corynebacterium | |||||||||||||

| 
| ||||||||||||
| Corynebacterium pseudodiphtheriticum Грам әдісімен боялған | Коринебакагардағы өсіндісі | ||||||||||||

|
| ||||||||||||
| Corynebacterium xerosis Грам әдісімен боялған | Қанды агардағы өсіндісі | ||||||||||||
| 35-сурет | |||||||||||||
| Actinomyces | |||||||||||||

| 
| ||||||||||||
| Грам әдісімен боялған | Тіндердегі друза | ||||||||||||

| 
| ||||||||||||
| Актиномицеттерден дайындалған жағынды. Грам әдісімен боялған | |||||||||||||
|
| ||||||||||||
| Сарысулы қанды агарлардағы актиномицеттер өсіндісі | |||||||||||||
| 36-сурет | |||||||||||||
| Bifidоbacterium | |||||||||||||

| 
| 
| |||||||||||

| |||||||||||||
| Балғын дақыл | Ескірген дақыл | Блаурокк ортасындағы өсіндісі | |||||||||||
| 37-сурет | |||||||||||||
| Gardnerella vaginalis | |||||||||||||

|
| ||||||||||||
| Грам әдісімен боялған | Қоректік ортадағы өсіндісі | ||||||||||||
| 38-сурет | |||||||||||||

| 
| ||||||||||||
| Pr Pc Дисульфиді, глизирленген домендермен және GPI якорымен байланысқан Pr Pс cүлгісі | Прионның үшіншілік құрылымының үлгісі | ||||||||||||
| 41-сурет | |||||||||||||

| 
| ||||||||||||
| Microsporum canisтің таза дақылы | Microsporum ferrugineumның таза дақылы | ||||||||||||
| 42-сурет | 43-сурет | ||||||||||||

| 
| ||||||||||||
| Trichophyton violaseumнің таза дақылы | Trichophyton rubrumның таза дақылы | ||||||||||||
| 44-сурет | 45-сурет | ||||||||||||

| 
| ||||||||||||
| Р.boydiiдің таза дақылы | Histoplasma capsulatumның таза дақылы | ||||||||||||
| 46-сурет | 47-сурет | ||||||||||||

| 
| ||||||||||||
| Cryptococcus neoformans | Coccidioides immitis | ||||||||||||
| 48-сурет | 49-сурет | ||||||||||||
| Candida albicans саңырауқулақтары | |||||||||||||
|
| ||||||||||||
| Грам әдісімен боялған | Сабура ортасындағы өсіндісі | ||||||||||||

|
| ||||||||||||
| Эпителиялық жасушаға кандиданың жабысуы | Никкерсон ортасындағы өсіндісі | ||||||||||||

| |||||||||||||
| Бластоспоралар. | |||||||||||||

| 
| ||||||||||||
| Хламидоспоралар. Жүгерілік агардағы өсіндісі | Жалған мицелиялар | ||||||||||||
| 50-сурет | |||||||||||||

| |||||||||||||
| Candida albicans | |||||||||||||
| 51-сурет | |||||||||||||

| 
| ||||||||||||
| A.fumigatus | Aspergillus | ||||||||||||
| 52-сурет | |||||||||||||

| 
| ||||||||||||
| P.marrneffei | Fusarium | ||||||||||||
| 53-сурет | 54-сурет | ||||||||||||

| |||||||||||||
| Қарапайымдылардың ультрақұрылымы. А-қандағы трепоносома, Б-токсоплазма, 1-коноидты ұшы, 2-микронемалар, 3- роптри; 4-микропора; 5-май тамшылары; 6-ядро; 7-эндоплазмалық тор; 8-пластикалық комплекс; 9-митохондрий. В-лямблия; 1-ядро; 2-дискоидты ядро; 3-цитоплазма; 4-талшық; 5-аксостиль; Г-балантидий; 1-цитосом; 2-цитофаринкс; 3-асқорыту вакуолі; 4-жиырылғыш вакуоль; 5-макронуклеус; 6-микронуклеус; 7-анальдық саңылау; 8-вакуолі. Д-қандағы лейшмания, Е-лейшмания құрылысы. | |||||||||||||
| 55- сурет | |||||||||||||
| Қарапайымдылар | |||||||||||||

| 
| ||||||||||||
| Лямблия цисталары | Lamblia intestinalis | ||||||||||||
| 42-сурет | |||||||||||||
Кейбір аурулардың қазақша атауларының орысша баламасы
Аусыл - Ящур
Алапес - Лепра
Ащы ішектің қабынуы – Энтерит
Ащы ішек пен тоқ ішектің қабынуы -Энтероколит
Бадамша бездің қабынуы – Тонзиллит
Баспа - Ангина
Боғмала - Актиномикоз
Ботулизм (астан улану) – Ботулизм
Бөртпе сүзегі – Сыпной тиф
Бүйрек астауының қабынуы - Пиелит
Газды гангрена – Газовая гангрена
Жапондық энцефалит -Японский энцефалит
Жатыр ернеуінің қабынуы – Цервицит
Жәншәу - Скаралатина
Жел шешек- Ветряная оспа
Жерше - Шигеллез
Иксод кене боррелиозы – Иксодовый клещевой боррелиоз
Кенелік энцефалит - Клещевой энцефалит
Күйдіргі – Сибирская язва
Күл, қырылдауық, құрөзек - Дифтерия
Күлдіреуік - Пемфигус
Көк тамырдың қабынуы - Флебит
Құзды таулар ақтандақтық қызба – Пятнистая лихорадка скалистых гор
Құтыру- Бешенство
Қызамық- Краснуха
Қызылша- Корь
Қырым Конго геморрагиялық қызба- Крымская (Конго) геморрагическая лихорадка
Лайм ауруы – Лаймская болезнь
Листериоз - Листериоз
Марселдік қызба – Марсельская лихорадка
Ми қабығының қабынуы -Менингит
Микоплазмоз – Микоплазмоз
Мысқыл- Эпидемический паротит (свинька)
Оба – Чума
Омбылық геморрагиялық қызба- Омская геморрагическая лихорадка
Оппортунисттік аурулар - Оппортунистические инфекции
Ортаңғы құлақтың қабынуы – Отит
Өкпе қабынуы - Пневмония
Өкпеқаптың қабынуы - Плеврит
Қылау (парасүзек) - Паратиф
Сары қызба- Желтая лихорадка
Соз – Гонорея
Солтүстік азиялық кенелік бөртпе сүзегі – Североазиатский клещевой сыпной тиф
Сом, көршиқан – Карбункул
Терінің іріңді ауруы –Пиодермия
Сіреспе - Столбняк
Туберкулез (құрт ауруы) - Туберкулез
Тұмау- Грипп
Тырысқақ – Холера
Тік ішектің айналасының қабынуы – Парапроктит
Тілме - Рожа
Ұшық- Герпес
Үрпі түтігінің қабынуы – Уретрит
Іріңдік -Абсцесс
Іш сүзегі – Брюшной тиф
Ішек иерсиниозы – Кишечный иерсиниоз
Хламидиоз - Хламидиоз
Шешек- Оспа натуральная
Шиқан, сыздауық – Фурункул
Эндемический возвратный тиф (клещевой возвратный тиф, аргасовый клещевой боррелиоз)-Эндемиялық қайталама сүзек (кенелік қайталама сүзек, аргас кене боррелиозы)
Эпидемиялық (бүргелік) бөртпе сүзек – эпидемический (блошиный) сыпной тиф
Эпидемиялық қайталама сүзек - эпидемический возвратный тиф
Қолданылған әдебиеттер
1. Амереев С.А. и соавт. – Стандарты и алгоритмы мероприятий при инфекционных заболеваниях. Практическое руководство. Алматы, 2007. 595 бет.
2. Амереев С.А., и соавт. – Стандарты и алгоритмы мероприятий при инфекционных и паразитарных болезнях. Алматы, 2008г. Практическое руководство. Том 2. 844 стр.
3. Арықпаева Ү.Т. және соавт – Микробиология және вирусология (жалпы бөлім). Оқу құралы. Алматы, 2005. 207 бет.
4. Ахметов М.А. Русско-казахско-английский медицинский словарь. Из-во «Сөз-Слово», Алматы, 2006. 512с.
5. Әлмағанбетов Қ.Х., және соавт - Микроорганизмдер биотехнологиясы.- Астана, 2008.- 2406
6. Әлмағанбетов Қ.Х.,- Биотехнология негіздері. - Астана, 2007, 208бет.
7. Әміреев С.А.. – Эпидемиология. Оқулық. Алматы, 2007, 450 бет.
8. Әміреев С.А., және соавт - Медициналық паразитология.- Алматы . Кітап баспасы , 2005, 421 бет.
9. Әміреев С.А, және соавт. - Жұқпалы аурулардың стандартты анықтамалары және іс- шаралар алгоритмдері. Практикалық нұсқаулық. 1 том. Алматы, 2009. 634 бет
10. Беспалова Ғ.И., және соавт.- Дифтерия (биология возбудителя и микробиологическая диагностика) - Учебное пособие предназначено для врачей-бактериологовб эпидемиологов, клиницистов, студентов медицинских вузов. Санкт-Петербург, 2006. 31с.
11. Волина Е.Г. Саруханова Л.Е. - Основы общей микробиологии, иммунологии и вирусологии. Учебное пособие. - М. ГЭОТАР- Медиа, 2007, 192с.
12. Воробьев А.А. - Микробиология и иммунология. Учебник.- 2-ое издание., перераб. и доп. - М. ОАО Издательство Медицина , 2005, 496с. (учебная литература для студентов медицинских вузов)
13. Воробьев А.А., Быков А.С. - Атлас по медицинской микробиологии, вирусологии и иммунологии. Учебное пособие для студентов медицинских вузов. М. Медицинское информационное агентство, Москва, 2003, 236с
14. Воробьев А.А., и соавт. - Медицинская и санитарная микробиология.: Учебное пособие для студентов медицинских вузов. 2-ое издание, М. Издательский центр «Академия», 2006. 464с
15. Горячкина Н.С., Кафарской Л.И. - Частная медицинская вирусология. Учебное пособие. Ростов на –Дону. Феникс, 2007. 206с.
16. Йоргенсен Дж. X., Пфаллер М.А. - Микробиологический для клиницистов : пер. с англ. М. Мир, 2006, 243с
17. Кәрімов С.. – Вирустар әлемі (эпидемиологиялық сипаттамасы, оқиғаның стандарттық анықтамасы, емдеу және алдын–алу шаралары). Оқу - әдістемелік құрал. Алматы, 2009. 156 бет.
18. Котова А.Л. - Клиническая микробиология. Методическое указание . Алматы, 2004, 162с.
19. Котова А.Л. - Нормофлора и дисбактериозы человека. Алматы, ТОО « Люкс Биндер Сервис», 2008, 512с
20. Котова А.Л., и соавт. - Возбудители микозов человека. Учебно – методическое пособие. Алматы, 2010. 40 с.
21. Лабинской А.С., и соавт. - Частная медицинская микробиология с техникой микробиологических исследований. Учебное пособие (учебная методичка для слушателей системы последипломного образования). М. ОАО «Издательство Медицина» , 2005. 600с
22. Марри П.Р., Шей И.Р. - Клиническая микробиология. Краткое руководство, перев с англ. М. Мир,2006, 425с.
23. Маянский А.Н. - Патогенетическая микробиология, руководство. Н.Новгород. Издательство Нижегородской государственной медицинской академии, 2006. 520с
24. Мудрецова -Висс К.А., Дедюхина В.П. - Микробиология, санитария и гигиена. Учебник, 4-ое издание., испр. и доп. - М.: ИД « Форум» ИНФРАМ, 2008. 400с.
25. Муминов Т.А., Рахишев А.Р. - Медицинский словарь (русско- казахскии). Алматы,2003. 352 с
26. Мұсабаев Ғ.Ғ. - Орысша - казақша сөздік - Алматы , 1978, 575 бет.
27. Павлович С.А. -Микробиология с вирусологией и иммунологией. Учебное пособие, Мн. Высшая школа, 2005, 799с
28. Подколзина В.А., Седов А.А. - Медицинская микробиология, Конспект лекций. М. Издательство Эксмо, 2006, 160с
29. Поздеев О.К. - Медицинская микробиология. Учебное пособие. 4-ое издание испр. М.:ГЭОТАР - Медиа, 2005, 768с (серия «XXI век»)
30. Райкис Б.Н., и соавт. - Частная микробиология. Бактериология (в графическом изображении) Учебное пособие. М. Триада -X Москва. 2006. 376с
31. Рамазанова Б.А., және соавт. - Жалпы микробиология. Оқу - әдістемелік құрал. Алматы, 2008. 391 бет.
32. Рамазанова Б.А., және соавт. - Жеке микробиология. Оқу